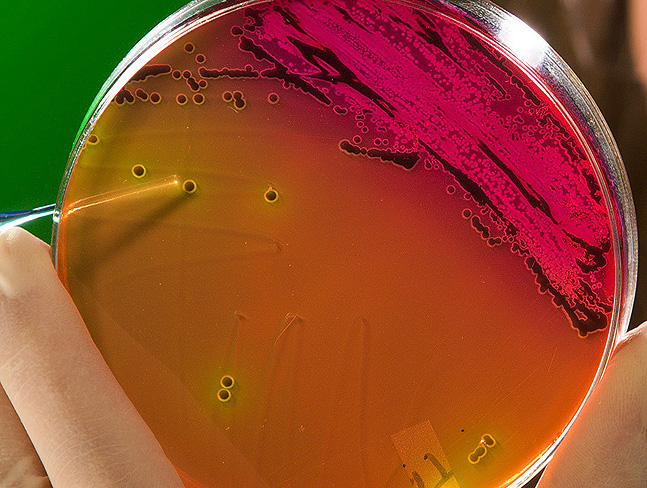
ARS is working with other government agencies to study bacteria in an interdisciplinary approach to mitigate antimicrobial resistance.

…Watch Albert’s Cooking Show: www.foodytv.com or stream it on Roku, Amazon Fire, Google TV and apple TV Follow Albert on: Facebook, LinkedIn: Albert J. Hernandez the Untamed Chef IG: untamedchef777…
NASCAR Will Surpass 10 Million Miles on Biofuel
…in Florida back in 2011. “As we approach 10 million miles, it’s evident that the renewable, higher ethanol blended fuel performs flawlessly against rigorous racing conditions,” said Brent Dewar, Chief…
Canada Makes Big Investment in Dairy Industry
…away with all the damage they say will be caused by the Canada-European Union Comprehensive Trade Agreement, or CETA. The Dairy Farmers of Canada say CETA will result in up…
The California Kitchen: Garlic Scalloped Potatoes
…directions, listen to today’s California Kitchen from AgNet West. Ag Net Garlic 5 2016 For this and many more of these recipes visit: www.ajhtheuntamedchef.com Watch Albert’s Cooking Show: www.foodytv.com or…
Ranchers see Better Pastures, Tough Markets
…so much feed on the ground currently, there’s even less demand for hay, keeping that market down, he said. “These prices really rocked us pretty good,” Stone said. “We went…
Bird Flu Discovered in European Union
…been reported in Germany, Hungary, Poland, Switzerland, and Austria. German, Swiss, and Austrian authorities are currently coordinating containment efforts as wild birds can transmit the virus to poultry on the…
Environmental Regulations Early GOP Target
…the Oval Office. Republicans in Congress have certain things on their wish list as well: no federal regulations on fracking, no federal greenhouse gas regulations, as well as expanding development…
Acreage Planting Switch Possible in 2017
…acreage switch will be determined in part by crop demand for those commodities in the new year. Producers saw an unusually good planting window in 2016, but a return to…
The California Kitchen: Pickled Garlic Cloves with Sweet Peppers
…Kitchen from AgNet West. The California Kitchen For this and many more of these recipes visit: www.ajhtheuntamedchef.com Watch Albert’s Cooking Show: www.foodytv.com or stream it on Roku, Amazon Fire, Google…
‘One Health’ Antibiotic Awareness
…research agency—investigate antibiotic resistance in animals, fish, water, air, soil, manure and plants. For example, ARS animal-health experts reduce drug resistance by developing antibiotic alternatives. ARS food-safety experts study bacterial…
Mushroom Council Members Named
…members are Michael A Stephan, of Chaska, Minn., and Robert Murphy, of Colusa, Calif. Newly-appointed member Robert Besix is from Toughkenamon, Penn. Board members selected by the U.S. Secretary of…
Incentives to Grow the Bioeconomy and Improve Forest Health
…the foundation for more bioproducts made in rural America, supporting rural economic development, reducing carbon pollution and helping decrease our dependence on foreign energy,” said Dolcini. In fiscal year 2017,…
Almond Board: Almond Conference Sessions
…global and local marketing programs. Attendees of The Almond Conference can expect to network with key leaders of the almond industry, including decision-makers, buyers, growers, handlers and industry experts. As…
Ag Groups React to New GIPSA Rules
…were passed along to the Office of Management and Budget, and if they’re approved, they’ll be announced for public comment. The Pig Site dot com website says a letter from…